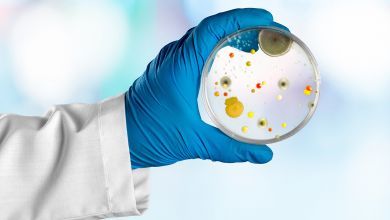

SAĞLIK
-

-
birpufnoktasi0 419Bir kişinin beyin kanaması geçirdiğini bu 4 basit yöntemle anlayabilirsiniz
Bir kişinin beyin kanaması geçirdiğini nasıl anlayabilirsiniz
-
birpufnoktasi0 660Nar kabuğunun saça faydaları nelerdir? Nar kabuğu saça nasıl uygulanır?
bağışıklık sitemini güçlendirmeden kanser hücrelerini yok etmeye kadar bir çok hastalığın önüne geçiyor. Son yıllarda kozmetik sektöründe adını sıkça duyduğumuz…
-
birpufnoktasi0 503Kadınlarda daha sık görülen demir eksikliği (Anemi)’nin belirtileri
Demir eksikliği (Anemi)'nin belirtileri
-
birpufnoktasi0 2.444VÜCUTTAKİ ENFEKSİYON VE PARAZİTLERİ YOK EDİN
Vücudunuzdaki Enfeksiyonu ve Parazitleri Yok Edin!
-

-

-
birpufnoktasi0 346Bir kalp Cerrahından Yüksek Tansiyon İçin Ev Yapımı Doğal Reçete
Yüksek Tansiyon İçin Ev Yapımı Doğal Reçete
-
birpufnoktasi0 4235 Adet Ceviz Yiyin 4 Saat Bekleyin ve Marifetini Görün
5 Adet Ceviz Yiyin 4 Saat Bekleyin Marifetlerini Görün
-
birpufnoktasi0 517Vücutta Biriken Zehirli Toksinleri 1 Gece de Atmak İçin Detoks Tarifi
Vücudunuzdaki Zehirli Toksinleri 1 Gece de Atın